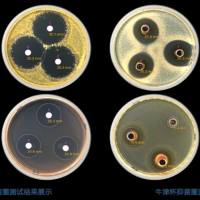
药物类抑菌实验

万千商家帮你免费找货
0 人在求购买到急需产品
- 详细信息
- 文献和实验
- 技术资料
一、技术简介:
用电生理仪器、电极、电压钳(voltage clamp)及膜片钳 (patch clamp) 技术等记录或测定整体动物或离体器官组织、神经和细胞离子通道等的电位改变、传导速度和离子通道的活动的技术即电生理技术。引导生物电的电极可分为大电极和微电极两类。大电极记录的是许多细胞(如一个器官)的电活动综合而成的生物电,如心电、脑电、肌电等。微电极尖端细小(直径<1微米),也可大至几微米 (玻璃管、金属丝) ,用微电极可在细胞水平上对生物电现象进行观测和研究。常用的电生理记录方法有细胞外记录、细胞内记录和膜片钳技术。
二、细胞外记录法:
细胞外记录法是将引导电极安放在神经组织的表面获取附近神经组织的电活动。生物体可兴奋细胞周围的细胞间液是具有长、宽、厚三维空间的容积导体,只要没有电流在容积导体中流动,容积导体各处的电位是相等的。当细胞兴奋时,由于兴奋部位的神经元去极化而不活动的部位处于正常极化状态,因而在容积导体中两部位间电位不同,电流从一点流向另一点。此时置于表面的电极即可记录出两者之间所产生的电位差。从容积导体中某一点记录到的电位是远处和近处许多单位活动的合量。
细胞外记录所得到的电位幅度大小和波形因细胞以及电极位置不同而异,因此,对胞外记录电位的分析着重于放电数目,一般不去比较放电幅度的大小。根据所用电极的不同,细胞外可记录到峰电位Spike(微电极)和场电位(大电极)。
1、峰电位Spike:神经元是神经活动的最基本单位,大多数神经元之间通过发放峰电位(Spike)进行信息交流。由膜电位变化产生的波峰即为峰电位Spike或动作电位,其在轴突上传导形成神经冲动。神经冲动编码方式类似于莫斯编码,编码方式不是spike的幅值,而是通过spike的频率,以及spike之间的间隔时间来编码。大脑神经元胞外单细胞峰电位的检测与分类是许多脑功能研究的前提。峰电位记录可分为胞外神经信号记录和胞内神经信号记录两种。胞外神经信号峰电位记录通常在目标神经元细胞外临近处放置一个信号记录电极,同时在细胞外较远处放置另一个电极作为零电位点,通过记录两个电极间的电位差得到神经信号。尽管相对于原始的动作电位(~70mV)),通过细胞外液体等介质传导至电极后的电位差会有2-3个数量级的衰减(~100uV),但是通过低噪声仪表放大器放大后,仍然能用它来表征峰电位的发放与否。通常,用微电极细胞外记录方式得到的电信号是同一脑区内许多神经元的发放。通过峰电位检测与分类算法可以较精确的将不同神经元发放的峰电位区分开,使之与发放它们的神经元相对应。这一点对于应用峰电位的发放时间进行的神经编码研究尤其重要。
2、诱发电位/场电位:中枢神经的任何部位对于故意刺激感受器官、感受神经、感觉通路上任意一点,或与感觉器官有关的任何结构上的任意一点所产生的电变化,叫做诱发电位,也称为场电位,它常出现在自发放电的背景上,不是单细胞放电,而是由许多突触后电位总和而成。该动作电位有形式恒定、一定的空间分布及与刺激有锁时关系三个特征。大脑皮层自发的电位活动称为脑波,当给身体某种刺激产生大脑电位活动的改变,由头皮引导出的电位称大脑诱发电位;由感觉刺激(光、声音、触觉等)引起大脑某部位表现出电变化称为感觉性诱发电位,主要包括视觉诱发电位、听觉诱发电位及躯体感觉性诱发电位;由肢体运动而出现的电位变化称为运动性诱发电位。
三、容积导体内记录法: 1、肌电图(Electromyogram, EMG):EMG记录肌肉活动时的动作电位,是测定整个运动系统功能的一种手段。在活体内,当肌肉收缩时,动作电位可从肌纤维经组织的导电作用反映至皮肤表面。在皮肤表面放两个金属电极或将针电极直接插入肌肉内,可记录到肌肉活动时的动作电位。EMG测定一般分为4个观察步骤:插入电位、静息期、轻收缩时的运动单位电位MUP以及募集电位。临床及科研中可用来判定神经、肌肉所处的功能状态,即骨骼肌纤维受神经支配的状况,以及神经肌纤维本身的状态,有助于对运动神经、肌肉疾患的诊断。
2、脑电图 (Electroencephalography, EEG) :EEG是研究大脑电活动最古老和最广泛使用的方法之一。人类或脊椎动物在安静情况下,即使没有任何特定刺激,在脑表面也能记录到持续节律性的电位变化,这种电位变化称为脑的自发电活动或脑电图。头皮脑电图(EEG)由单个电极记录头皮表面的电活动,是时空平滑版的局部场电位 (LFP),在10平方厘米或更大的面积上集成。在大多数情况下,它与单个神经元的放电模式没有明显的关系。EEG对异常脑活动敏感但不特异,EEG检查可发现脑部的弥漫或局限损害,对癫痫、脑炎、脑瘤及脑血管疾病等有一定诊断价值,特别对癫痫诊断帮助尤其大。
3、皮质电图 (ECoG):ECoG使用电极直接记录大脑皮层表面的电活动,通过使用灵活的,紧密间隔的硬膜下栅格或条状电极,记录电场的空间分辨率可以大大提高 (<5 mm2) 。
4、局部场电位(Local Field Potential):EEG、MEG和ECoG主要采集发生在皮层浅层的电活动。通过在大脑中插入金属或玻璃电极或硅探针可记录局部场电位LFP (也被称为“微EEG”),可以探索更深位置的电事件。神经元峰电位(Spike)是神经元活动时由膜电位变化产生的高频信号/动作电位,而LFP则是在电极尖端附近小范围区域内的突触后电位的平均效应,频域较广,可以分为很多频段,是电极周围细胞对该位置的共同作用。LFP的相位特征(特别是相位同步)是表达外界刺激信息的重要度量,Spike与LFP节律之间的锁相关系反映了重要的神经编码特性,通过锁相的研究可以进一步探究外部信息在中枢神经系统传递的特性以及整合机制。场电位信号对传递信息的编码方式通常有时域编码和频域编码两种。
相对于胞内记录技术,胞外信号记录具有三大优势:
1)操作更简单;
2)能够同时得到局部场电位LFP,它主要来自电极附近局部区域的神经元突触活动的总和,表征了区域内多个神经元协同工作的信息;
3)可以由单电极拓展到多通道的电极阵列 ( Multi-electrode array , MEA )。
因此可以同时记录到大脑同一功能区块中的不同区域、不同深度的多个神经元峰电位的发放。通过研究多个神经元在某一时刻的活动,能够更好的了解神经网络的结构、连接以及时序;同时,也可以通过控制(刺激)特定的若干个神经元,来观察神经网络中其他神经元的响应。基于上述三个优点,胞外神经信号记录是目前使用最广泛、最理想的电生理记录技术。
四、在体多通道电生理技术:为了获得高空间分辨率,Spike和LFP需要许多观察点,这些观察点之间距离设置要比较短,且对脑组织的影响最小。原则上,可以用足够大的记录位点密度来监测小体积中几乎所有或至少一个具有代表性的神经元种群的峰值活动。
在体多通道电生理记录技术又称为中枢神经元放电的在体多通道同步记录技术,是动物在更接近自然的状态下利用细胞外记录方法观察不同中枢的电活动,来监测神经元群的同步电活动。这一方法可以同步记录多个脑区的大量神经元的电活动,便于研究个体在接受某一感觉刺激或执行特定行为任务时,不同脑区的神经元放电在时间和空间上的联系,进而通过分析神经元的放电模式来研究大脑对外部事物的编码机制。
五、细胞内记录:
细胞内记录是研究神经元基本生物物理特性的有力手段。它需要通过精细的操作,将信号记录电极直接插入神经元细胞内,采集细胞内与细胞外(放置零电位电极)的电位差,最终记录到单个细胞在行为活动或环境影响下细胞膜电位变化。该方法的优势在于相对细胞外记录有更高的信噪比,可以准确测量膜电位、兴奋性突触后电位(EPSP)、抑制性突触后电位(IPSP)以及动作电位等多项电位指标。此外,还可以同时向记录电极中充灌染料(如辣根过氧化物酶)、携带荧光蛋白的病毒等,在记录结束后注入到所记录的细胞内,以观察此细胞的形态特征、投射部位或所处的神经环路。细胞内记录的缺点在于只能采集到单个神经元信号,因此在目前趋于研究神经网络活动,神经元记录数目越来越大的大趋势下,胞内神经信号记录技术的用武之地越来越少。
六、膜片钳:
细胞的跨膜电流是通过膜上的离子通道流动的。离子通道是细胞内部与外部环境联系的通道,是神经、肌肉和其他组织兴奋性和生物电的基础。单个通道开放时所流过的离子流的速度可增加14个数量级,离子转运的速率可达109个/s,此时所能转移的离子电流量只相当于几个皮安。而通常细胞内微电极测量电流时所伴有的背景噪声却至少为100皮安。这种显然极负的信噪比几乎构成了以单个通道为目标的电生理学测量的不可逾越的屏障。膜片钳技术巧妙解决了这一难题。该技术通过将玻璃微电极和只含1-3个离子通道,面积为几各平方微米范围的细胞膜通过负压进行吸引封接。由于电机尖端与细胞膜的高阻抗封接,使电极尖端所吸引的小片细胞膜与其周围在电学上分隔,因此膜片上通道开放所产生的电流可流进玻璃微电极,在此基础上固定电压再对此膜片上离子通道的离子电流进行监测记录。
七、电生理技术的应用范围:
1)记录生理、病理或刺激(物理、化学处理)前后胞内和胞外神经元活动;
2)特定神经细胞类型的电学特性研究;
3)特定脑区对外周传入刺激或内脏传入的反应;
4)药物的药理学机制研究。
八、服务流程:
需求沟通→方案定制→样本准备→电极制作→电极植入→信号记录→数据分析→交付结果。
九、需提供材料及信息:1)详细的实验需求及参考资料;
2)实验模型/样本,保证样本质量;
3)分析需求。
十、结果交付内容:
1)检测报告;
2)原始数据。
风险提示:丁香通仅作为第三方平台,为商家信息发布提供平台空间。用户咨询产品时请注意保护个人信息及财产安全,合理判断,谨慎选购商品,商家和用户对交易行为负责。对于医疗器械类产品,请先查证核实企业经营资质和医疗器械产品注册证情况。
文献和实验佚名 心肌组织具有兴奋性、自律性、传导性和收缩性四种生理特性。心肌的收缩性是指心肌能够在肌膜动作电位的触发下产生收缩反应的特性,它是以收缩蛋白质之间的生物化学和生物物理反应为基础的,是心肌的一种机械特性。兴奋性、自律性和传导性,则是以肌膜的生物电活动为基础的,故又称为电生理特性。心肌组织的这些生理特性共同决定着心脏的活动。 (一)心肌的兴奋性
近几年光遗传学在电生理领域非常火热,在不了解它之前相信很多人会觉得很高端,很难懂。在我们了解之后会发现其实它很简单,只是一种工具的应用: 通过基因工程,科学家构建出了携带有特定种类视蛋白基因的病毒载体,用它们感染培育好的实验动物,再通过各种操作将视蛋白特异性表达在某一类神经细胞上。这样一来,一类新的转基因实验动物诞生了,它们脑内将有且仅有这一类神经细胞对光敏感。 视蛋白是一种对光敏感的独特蛋白,也就是附着于细胞膜上的光敏感离子通道,在受光刺激后打开
相关专题蛋白质组蛋白质组(proteome)一词是澳大利亚科学家Williams和Wilkins于1994年首先提出的,它是指一个细胞或一个组织基因组所表达的全部蛋白质总和,是对应于一个基因组的所有蛋白质构成的整体。短短20年间,蛋白质组的研究取得了惊人的进展,这相当程度上要归功于质谱技术在蛋白质组中的应用和不断发展。同时,蛋白质组和基因组的发展是相辅相成的,凡是经过基因组测序的物种,都可以用质谱技术大规模鉴定其蛋白质组成。当前,比较主流的蛋白质组学研究方案当属LC-MS/MS系统, LC
技术资料暂无技术资料 索取技术资料